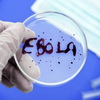

ПОПУЛЯРНОЕ ВЧЕРА ОБСУЖДАЮТ

МЫШЕЛОВКА ЗАХЛОПНУЛАСЬ? УЭК (БИОМЕТРИЧЕСКИЙ ПАСПОРТ) – ОКОНЧАТЕЛЬНОЕ ОТРЕЧЕНИЕ ОТ ХРИСТА, ДАЛЕЕ – ЗОМБИРОВАНИЕ И ПЕЧАТЬ
Главные новости / Публикации / Православие / Глобализация / Апостасия / Апокалипсис / Эл.концлагерь / УЭК | 20 августа 2012
0
1 100 845

Эпидемия лихорадки Эбола: мировое сообщество организовало контролируемый хаос?США усиливают меры контроля при въезде в страну. В Германию доставлен третий пациент, зараженный вирусом Эбола. Политики во всем мире ищут решение проблемы. Глава Всемирного банка Джим Ен Ким заявил, что в борьбе против смертоносного вируса Эбола международное сообщество «потерпело фиаско»...Ученые считают что лихорадка Эбола скоро доберется до ЕвропыУченые из Северо-восточного университета Бостона предсказали скорое распространение лихорадки Эбола в Европе. По их словам, первые заболевшие могут появиться уже к концу октября. Эксперты изучили маршрут распространения болезни и данные авиакомпаний об осуществляемых перелетах. В результате по прогнозам ученых...Будьте готовы к неожиданностям: Мегаземлетрясения свыше 9,0 приближаются?Никто не должен быть удивлен, если мегаземлятрясение силой 9 баллов произойдет на Западном побережье Америки или в другом месте вокруг Тихого океана в так называемом «Огненном кольце», если на то пошло. Такой вывод делает новое исследование, результаты которого опубликованы в...Геологическая служба США связала участившиеся землетрясения с добычей сланцевого газаЭксперты Геологической службы США заявили, что технологии по добыче сланцевого газа при помощи гидроразрыва подземных пластов под высоким давлением могут быть причиной землетрясений. После того, как энергетические компании при помощи таких технологий стали добывать газ в штатах Колорадо и Нью-Мексико...Привет электронизаторам из космоса. На Солнце произошла мощная вспышкаНа поверхности Солнца произошла мощнейшая с 2012 года вспышка, направленная в сторону Земли, сообщает портал CBS News. Как сообщает издание, нынешнее солнечное возмущение может повредить системы энергоснабжения, а также нарушить спутниковую и радиосвязь...США: Сланцевая "революция" продолжает уничтожать сельское хозяйствоДва железнодорожных картеля США - BNSF Railway (владелец - Уоррен Баффет) and Canadian Pacific (владелец - Билл Гейтс) почти монополисты для большинства фермеров Дакоты, Миннесоты и Висконсина по вопросу доставки зерна к рынкам сбыта. Сейчас они "забили" на зерно и первым приоритетом рассматривают сланцевую нефть...Мир ждет глубоководный "сланцевый" бум?Энергетические компании начинают масштабный перенос операций по разработке сланцевых месторождений в районе, где возможна только глубоководная добыча. В частности, такие операции планируется развернуть у берегов США, Южной Америки и Африки. Использование гидроразрыва пласта стало одной из самых выгодных технологий по...Последнее китайское предупреждение? Ураган на падаре ВМСУ в Одессе. (ВИДЕО)После военного парада в Киеве Порошенко прибыл в Одессу и принял там военно-морской парад. По словам П.Порошенко, Одесса с полным правом может называться морской столицей Украины, где базируется не только военный, но и торговый флот страны. Украина "была, есть и будет морской державой", заявил президент Украины Петр Порошенко...Новая экологическая угроза на Донбассе: остановлены предприятия «Метинвеста»Представители группы «Метинвест» (принадлежит Ринату Ахметову) заявили 18 августа о том, что на Донбассе из-за артиллерийских обстрелов, повредивших линии электропередачи, остановлено 4 предприятия: Енакиевский металлургический завод (ЕМЗ), Енакиевский Коксохимпром (ЕКХП), Харцызский трубный завод (ХТЗ) и Авдеевский...«Ситрол»: Обстрелы химзавода в Горловке грозят гибелью жителям УкраиныЕсли украинские силовики продолжат артиллерийские обстрелы и бомбардировку территории концерна «Ситрол» в Горловке, то это может привести к катастрофическому выбросу ядовитых веществ что повлечет гибель жителей не только Украины, но и сопредельных России и Белоруссии, сообщил в воскресенье пресс-секретарь концерна Павел Брыков...ЧТО ОНИ ТАМ РАСПЫЛЯЮТ? Документальный фильм о химтрейлах (ВИДЕО)Фильм о химиотрассах и химтрейлах, о том что начали распылять некоторые самолеты у нас над головами после открытия воздушного пространства... В этом документальном фильме вы узнаете, как распыляемые в нашем небе аэрозоли используются в сочетании с другими технологиями для управления нашей погодой. Геоинженеры утверждают...Последствия добычи сланцевого газа в Америке (ВИДЕО)Уже почти 10 лет Соединенные Штаты сотрясает «Сланцевая лихорадка» – на углеводородах из сланцев нефтегазовые гиганты и биржевые спекулянты зарабатывают более $20 миллиардов в год. Расплачиваются за это миллионы простых американцев. Добычу сланцевого газа методом гидроразрыва специалисты приравнивают к экологическому терроризму...В Среднечешском крае вымирают пчелыКолониям пчел в Среднечешском крае угрожает вирусная эпидемия, седьмая по счету в этом году. Карантин объявлен среди пчеловодов в более чем сотне небольших городов и поселков региона. Поскольку в государстве лечение таких пчел запрещено, болеющие семьи изолируются, а затем уничтожаются, передает «Радио Прага»...В ЛНР сообщили о попытке Киева отравить водоемы республикиРуководство Луганской народной республики, основываясь на сводках министерства обороны, предположило, что Киев предпринял попытку отравить территорию и водоемы в районе поселка Бирюково. Как отметили в минобороны, военными неоднократно были зафиксированы факты обстрела поселка минами. Одна из них попала в...Украина: Психотропное химическое оружие - технологии ЦРУ в действииПо данным источников ФСБ РФ на Украине зафиксированы факты крупномасштабной манипуляции по «зомбированию» населения. На водозаборных станциях по обработке питьевой воды уже более полутора лет используется новый обеззараживающий материал поставляемый на Украину американскими химическими компаниями...Диверсия? В Полтавской обл. произошел взрыв на газопроводе Уренгой-Помары-УжгородВ районе г. Лохвица Полтавской области взорвался газопровод Уренгой-Помары-Ужгород. Об этом 112.ua сообщили в пресс-службе МВД Полтавской обл. По словам очевидцев, пламя поднялось на высоту около 200 метров. По предварительной информации жертв и пострадавших нет. "Взрыв произошел около 14:45 на газопроводе на территории поля...УкроСМИ готовят почву для применения бактериологического оружия? Санитарная служба Украины: Из-за поврежденного магистрального водопровода в Славянске может ухудшиться эпидемическая ситуацияЭпидемическая ситуация в целом в Украине ныне контролируемая, однако из-за повреждения магистрального водопровода в Славянске существует риск ее осложнения. Об этом среду заявил и.о. председателя Государственной санитарной эпидемиологической службы Украины Александр Кравчук, - сообщает Укринформ...Прекращен подвоз питьевой воды в СлавянскВ Славянск прекращен подвоз питьевой воды, сообщил в среду председатель государственной санитарно-эпидемиологической службы Украины Александр Кравчук. Он подчеркнул, что в зоне проведения спецоперации могут быть осложнения эпидемической ситуации — в районе города Славянска поврежден магистральный водопровод...Через 10 лет вода может стать причиной или орудием войны. (ВИДЕО)Cпецслужбы США прогнозируют, что менее чем через 10 лет вода может стать причиной или орудием войны. Особенно на Ближнем Востоке и в Северной Африке. Но кое-где это уже стало реальностью. Пример тому – Сирия. Боевики в Сирии используют воду как орудие борьбы против правительства. В прошлом месяце они нанесли удар по насосным...Град в Москве размером с орех. (ВИДЕО)На некоторые районы Москвы и области обрушился сильный град. По свидетельствам очевидцев, он достигал размеров вишни или ореха. На некоторые районы столицы и Подмосковья обрушился сильнейший град. По свидетельствам очевидцев, которые охотно делятся своими впечатлениями, его размеры можно было смело сравнить с вишней или орехом...РЕПОСТ ! Хунта хочет применить химическое оружие против Славянска«Министр обороны» Украины Коваль считает, что против Славянска бует применено химическое оружие. Ополченцы в Славянске готовятся подорвать емкости с отравляющими веществами. Об этом на брифинге, который транслировал телеканал «112 Украина», заявил глава Минобороны Михаил Коваль...Пророчества Паисия Святогорца сбываются. Турция перекрыла Сирии водуСогласно некоторым региональным источникам, 15 мая Турция полностью перекрыла сток вод Евфрата, в результате чего уровень воды в водохранилище «Асад» упал на 6 метров. Этот процесс начался ещё 1,5 месяца назад по приказу турецких властей, а в настоящее время из-за отбора водных ресурсов в Турции колодцы...На Афоне произошло землетрясение - Господь ответил на действия экуменистов в Иерусалиме? (ВИДЕО)Землетрясение магнитудой 6.5 произошло в субботу в Греции в 12:30 по местному времени. Эпицентр землетрясения находился между островами Лимнос, Самофракия и Имврос, — сообщает Путеводитель по Афону со ссылкой на amen.gr. Интенсивные толчки были ощутимы на Святой Горе Афон. Жертв и серьёзных разрушений нет, но по...Урожаю зерновых в России грозит засухаРиск ущерба урожаю начнет повышаться после 10 дней жаркой и сухой погоды. Глава Российского зернового союза Аркадий Злочевский сообщил, что продолжительная жаркая сухая погода в главных сельскохозяйственных районах России ставит под угрозу урожай этого сезона...Из-за наводнения в Боснии и Герцеговине эвакуирована четверть населения страныПредседатель Совета министров Боснии и Герцеговины Векослав Беванда заявил, что, по предварительной оценке, одна четверть населения страны, то есть примерно 950 тысяч человек были вынуждены эвакуироваться из-за наводнения, сообщает агентство «Синьхуа». Глава правительства БиГ заявил...Синяя смерть от "British Petroleum"Эти бактерии питаются нефтью - впрочем, и почти любой другой органикой тоже. Их клетки полностью искусственные, со сконструированным компьютером геномом, вообще не содержат какой-либо природной ДНК, зато содержат в себе особые цепочки «водяных знаков» с тем, чтобы геном опознавался как искусственный...Сербия и Босния запросили помощь мирового сообщества: ливни не прекращаются, ожидается резкое повышение водыБалканские страны продолжают страдать от наводнения, которое грозит не только жизням людей, но еще и энергетическим коллапсом. В ночь 19 мая солдаты и энергетики сложили тысячи мешков с песком, чтобы защитить крупнейшую электростанцию Сербии от паводка. Ожидается, что уровень воды продолжит повышаться после сильнейших...Православная Сербия терпит очередное страшное бедствиеПравославная Сербия, совсем недавно отметившая очередную годовщину разрушительных бомбардировок НАТО, вновь подверглась страшному бедствию – на сей раз на эту многострадальную, братскую для нас, страну обрушилось катастрофическое наводнение, которое в очередной раз разрушило востанновленные после натовских...Крымский бумеранг: Галичину затопилоПосле перекрытия Украиной Северо-Крымского канала на Западную Украину обрушились сильные ливни. Вода подтапливает дома, размывает дороги и железнодорожные пути, реки выходят из берегов. Во Львовской области из-за подтопления эвакуированы 759 человек, в том числе 119 детей. Об этом сообщает Госслужба Украины по чрезвычайным ситуациям...ООН признала опасность химиотрассМы уже не раз публиковали материалы по химиотрассам. В последнее время их со скрипом начинают признавать лишь отчасти, выдавая малую часть информации об использовании химикатов с целью изменения климата. Реальный геноцид населения земли с помощью химиотрасс гораздо масштабней... |